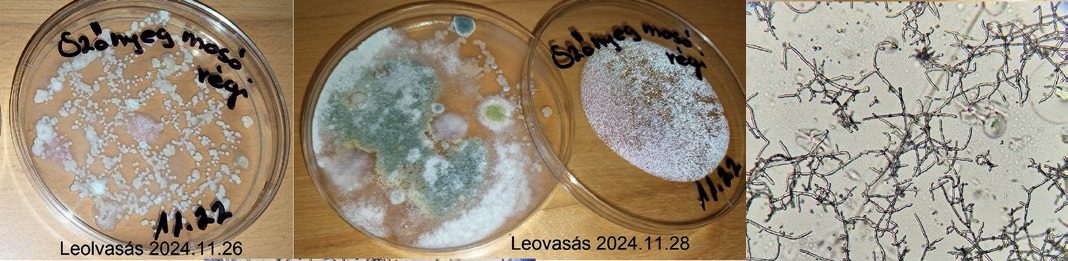
A képen ugyanaz a Petri-csésze láthatókét nap eltéréssel, valamint a Trichoderma mikroszkópos képe

Ez rövid távon megnyugtató, ha biztos lehetne abban az ágazat, hogy a gabonatermelők nem növelik a szárszilárdítók használatát, illetve, ha az EU hatósága nem változtatja, azaz nem csökkenti az MRL-értéket.
A rendszeres mérés nagyon fontos az élelmiszerbiztonság érdekében, mert bekerülhetnek a rendszerbe kockázatos, külföldi eredetű gabonaszalma-szállítmányok. Pár évvel ezelőtt a Bio-Fungi Kft. Szlovákiából származó szalmában mért magas értéket, ennek felhasználását le is állították. Lezárva ezt a gondolatot, elmondhatjuk, hogy a magyar gombaipar kitettsége a szárszilárdítók tekintetében nem kritikus. Rendszeres a monitoring, a kollégák felkészülten követik a folyamatokat és szükség szerint selejtezik azokat a szalmatételeket, amelyek veszélyt jelentenének a gomba élelmiszerbiztonsági minőségére.
Gombákra veszélyes Trichoderma
Egy másik szakmailag érdekes és ágazatok közötti kutatásra és egyeztetésre okot adó jelenség a Trichoderma-fajok megjelenése és károkozása a gombaiparban. A Trichoderma nemzetség fajai kozmopolita penészek, hétköznapi néven zöldpenészek, amelyeket egyre nagyobb területen alkalmaz az ökológiai növényvédelem. Használják talajfertőtlenítésre, vetőmagcsávázásra és kertészeti kultúrákban más patogén penészekkel szemben, antagonista biológiai védekezésként.
Kezdetben az itt-ott felbukkanó zöldpenészek jelentős károkozását kezelni lehetett az akkor még engedélyezett fungicidekkel, de évek múltán egyre agresszívabb változatok jelentek meg, amire az ágazatnak reagálnia kellett, illetve több vegyszer használatát megtiltották. Hazai és külföldi kutatók segítségével megtörtént a fajok genetikai alapú beazonosítása, az alfajok elkülönítése. Nem tudtuk teljes bizonyossággal megállapítani, honnan jöttek ezek az alfajok, azt viszont kizártuk, hogy genetikai módosítás következménye lenne a Trichoderma-törzsek sikeres elszaporodása a gombakomposztokban. Nagy szakmai kihívást jelentett, hogy ilyen hatékonyan meg tudnak élni egy bonyolult, mikrobiológiailag fermentált biomasszában, és a mai napig nem tudtunk komoly sikereket elérni.
Kizárólag a precízen működtetett gyártási, anyagmozgatási és légkezelés-technológiai higiéniával tudunk védekezni, amit rendszeres mikrobiológiai monitoringrendszerrel kell megtámogatni.
Ezért is vagyunk e cikk írójaként szkeptikusak, amikor biokészítmények, így Trichoderma-termékek megjelenéséről látunk cikkeket, marketinganyagokat. Ha készültek is hatástanulmányok, akkor a kérdés az, hogy tényleg sikerült-e lemodellezni a környezet összetettségét, és bizonyítható-e, hogy a vizsgálatokat elég hosszan folytatták. Azt tudjuk, hogy a legtöbbször a Trichoderma aggressivum var. europaeum faj okoz károkat a gombaiparban, és ilyen fajt tartalmazó biológiai növényvédelmi szert nem ismerünk.
A biológiai módszerek természetesen mindannyiunk által üdvözölt technológiák. Viszont tisztában kell lennünk azzal, hogy bármilyen organizmus, legyen az a természetből izolált vagy annak valamilyen tulajdonságára szelektált faj, tömeges visszajuttatása a természetbe, zárt termelőegységekbe vagy egyszerűen csak a szántóföldekre, beavatkozik a jelen levő mikroszervezetek egyensúlyába, számunkra ismeretlen kölcsönhatásokat kiváltva. Úgy véljük, ennek a teóriának a kutatása érdekes eredményeket hozhat, és válaszokat adhat a gombaiparban dolgozók kérdéseire.
Dr. Hajdú Csaba,
Amycel SARL.
Nagyné Fábián Hajnalka,
Bio-Fungi Kft.



